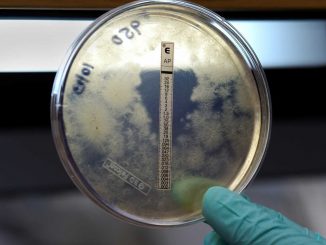

‘Digestive distress’ due to fatty liver could cause two major signs
Liver disease: NHS Doctor talks about link with alcohol We use your sign-up to provide content in ways you’ve consented […]
Liver disease: NHS Doctor talks about link with alcohol We use your sign-up to provide content in ways you’ve consented […] We use your sign-up to provide content in ways you’ve consented to and to improve our understanding of you. This […] This Morning: Dr Chris warns bad breath can indicate diseases We use your sign-up to provide content in ways you’ve […] What is the life expectancy in YOUR area? Interactive map reveals how average man born in Westminster will live to […] Dr Chris Steele shares diet tips on reducing blood pressure We use your sign-up to provide content in ways you’ve […] The prevalence of vertebral fractures is high among men with prostate cancer at the start of androgen deprivation therapy (ADT), […] Influential English guitarist Jeff Beck, who rose to fame playing with the Yardbirds and later fronted the Jeff Beck Group, […] Extracts from Prince Harry’s recently published memoir, “Spare,” reveal that he used a person with supposed psychic abilities to contact […] In a recent article published in The Journal of Clinical Investigation, researchers collated the findings of studies relating original antigenic […] Brain structures which could predict an individual’s predisposition to accidental awareness under anesthetic have been identified for the first time […]Health News

‘Digestive distress’ due to fatty liver could cause two major signs

Paramedic loses three colleagues to suicide as morale at ‘rock bottom’

Recurring ‘bad breath’ could signal three major conditions

What is the life expectancy in YOUR area?

Nation’s favourite foods could increase blood pressure by 17%

Many With Prostate Cancer Have Vertebral Fracture at ADT Onset
Jeff Beck dies of bacterial meningitis. What you need to know about the disease

A quarter of British people have consulted a psychic. Here’s the science on why

Recent findings on original antigenic sin and SARS-CoV-2

Predisposition to accidental awareness under anesthesia identified by neuroscientists
Copyright © 2026